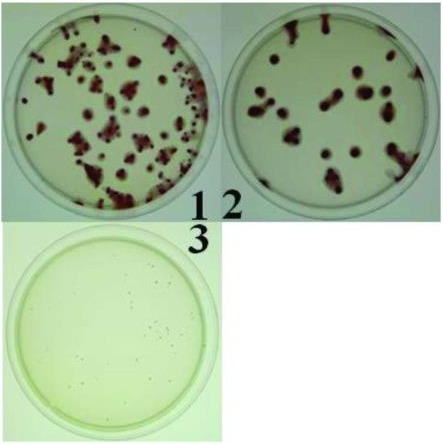

-
 화학.재료
화학.재료


- Ti2AlC의 제조방법 및 이를 이용한 전극재 및 고온 부품
- 등록번호 : 20-0490068
티타늄, 알루미늄, 전극재미래소재연구단 -
 화학.재료
화학.재료


- 구리-아스파르테이트-비스이미다졸 금속유기골격체를 촉매로 사용한 5원환 탄산염 화합물의 제조방법
- 등록번호 : 10-1825671
촉매, 탄산염, 이산화탄소, 에폭시화합물미래소재연구단 -
 화학.재료
화학.재료


- 가시광 흡광을 위한 코어-쉘 구조를 갖는 금속산화물-전이금속 광촉매의 제조방법
- 등록번호 : 10-1912585
광촉매, 가시광, 흡광, 금속산화물, 전이금속미래소재연구단 -
 화학.재료
화학.재료


- 원자-스케일 채널을 포함하는 입자, 이의 제조방법, 및 이를 포함하는 촉매
- 등록번호 : 10-2035215
촉매, 이산화탄소, 흡착, 전환미래소재연구단 -
 화학.재료
화학.재료


- 탄소질 구조체 및 이의 제조방법, 상기 탄소질 구조체를 포함하는 전극 재료 및 촉매, 상기 전극 재료를 포함하는 에너지 저장 디바이스
- 등록번호 : 10-1951821
탄소, 구조체, 전극, 촉매, 에너지, 디바이스미래소재연구단 -
 화학.재료
화학.재료


- 나트륨 바나듐 인산염계 전극활물질의 제조방법 및 그 방법으로 제조된 이차전지용 나트륨 바 나듐 인산염계 전극활물질
- 등록번호 : 10-1860404
나트륨, 바나듐, 인산염, 전극활물질, 이차전지, 배터리미래소재연구단 -
 화학.재료
화학.재료


- 공혼성화 나노복합체, 이의 제조 방법, 및 이를 포함하는 이산화탄소 흡착제
- 등록번호 : 10-1894780
이산화탄소, 흡착제, 나노, 복합체미래소재연구단 -
 화학.재료
화학.재료


- 혼성화 나노복합체, 이의 제조 방법, 및 이를 포함하는 수분 흡착제
- 등록번호 : 10-1876318
수분, 흡착제, 나노, 복합체미래소재연구단 -
 화학.재료
화학.재료


- 신규한 아연 함유 금속유기골격체 화합물 및 이를 촉매로 사용한 5원환 탄산염 화합물의 제조 방법
- 등록번호 : 10-1855297
탄산염, 촉매, 아연, 복합체, 흡착제, 고활성미래소재연구단 -
 화학.재료
화학.재료


- 마이크로 세공과 메조 세공을 동시에 갖는 ZON 구조의 알루미노포스페이트 또는 실리코알루미 노포스페이트의 제조방법 및 이에 의해 제조된 실리코알루미노포스페이트를 포함하는 수분흡착제
- 등록번호 : 10-1995164
수분, 흡착, 세공, 히트펌프, 에너지미래소재연구단 -
 화학.재료
화학.재료


- 나노 세공체 함유 유기 필름층을 갖는 기체 차단용 적층 필름, 이의 제조방법 및 용도
- 등록번호 : 10-1953732
나노, 세공체, 필름, 기체, 차단미래소재연구단 -
 화학.재료
화학.재료


- 비정질 금속 산화물 분말의 제조 방법 및 비정질 금속 산화물 분말을 이용한 광전자 소자
- 등록번호 : 10-1873150
금속, 산화물, 광전자, 소자미래소재연구단 -
 화학.재료
화학.재료


- 마찰교반용접 고주파 스핀들
- 등록번호 : 10-1886692
고주파, 스핀들, 용접미래소재연구단 -
 화학.재료
화학.재료


- 금속원자가 도핑된 유기금속-탄소 복합체 및 그 제조방법
- 등록번호 : 10-1881949
금속, 도핑, 유기금속, 탄소, 복합체미래소재연구단 -
 화학.재료
화학.재료


- 탄소나노입자-탄소재 복합체 및 그 제조방법
- 등록번호 : 10-1881945
탄소, 나노, 복합체미래소재연구단 -
 화학.재료
화학.재료


- 플라즈마 화학 기상 합성법을 활용한 탄소 기반 고 비표면적 나노 폼 소재 및 그 제조방법
- 등록번호 : 10-1867239
플라즈마, 탄소, 비표면적, 나노, 폼, 비정전용량미래소재연구단 -
 화학.재료
화학.재료


- 니켈산화물과 천공된 그래핀이 적용된 수퍼 캐패시터 용 전극 및 그 제조방법
- 등록번호 : 10-1858805
니켈, 그래핀, 커패시터, 전극미래소재연구단 -
 화학.재료
화학.재료


- 원자층증착법을 이용한 RuTaN 복합박막의 제조방법 및 이를 구비한 반도체 소자
- 등록번호 : 10-2048128
원자층, 증착, 루테늄, 탄탈륨, 박막, 반도체, 소자미래소재연구단 -
 화학.재료
화학.재료


- 염료―흑연 리튬이온 배터리용 음극재 및 그 제조방법
- 등록번호 : 10-2013530
염료, 흑연, 리튬, 배터리, 음극재미래소재연구단 -
 화학.재료
화학.재료


- 암호화 소자 및 시스템, 그리고 암호화 패턴 검출 방법.
- 등록번호 : 10-2002288
암호화, 소자, 패턴, 센싱, 검출미래소재연구단 -
 화학.재료
화학.재료


- 특정원소를 함유한 유무기화합물이 물리적으로 흡착된 탄소복합소재
- 등록번호 : 10-1997404
탄소, 탄소복합체, 그라파이트, 흡착미래소재연구단 -
 화학.재료
화학.재료


- 내부에 공동이 형성된 리튬-탄소 복합체 및 그 제조방법
- 등록번호 : 10-1989858
공동, 리튬, 탄소, 복합체미래소재연구단 -
 화학.재료
화학.재료


- 알루미늄-아연-구리(Al-Zn-Cu) 합금 및 이의 제조방법
- 등록번호 : 10-1974913
알루미늄, 아연, 구리, 합금미래소재연구단 -
 화학.재료
화학.재료


- 실리콘 나노입자를 포함하는 리튬이차전지용 음극활물질 및 그 제조방법
- 등록번호 : 10-1942922
실리콘, 나노, 리튬, 이차전지, 리튬전지, 음극, 음극활물질미래소재연구단 -
 화학.재료
화학.재료


- 2차원 박막 표면 처리 방법 및 이를 포함하는 전자 소자의 제조 방법
- 등록번호 : 10-1884977
2차원, 박막, 표면처리, 전자, 소자미래소재연구단 -
 화학.재료
화학.재료


- 비휘발성 메모리 소자 및 이의 제조방법
- 등록번호 : 10-2008158
비휘발성, 전극, 절연막, 메모리, 소자미래소재연구단 -
 화학.재료
화학.재료


- 터널링 전계효과 트랜지스터
- 등록번호 : 10-1966531
반도체, 터널링, 전계, 트랜지스터미래소재연구단 -
 화학.재료
화학.재료


- 2차원 맥세인 박막의 제조방법
- 등록번호 : 10-1966582
멕세인, 박막, 맥스상, 2차원미래소재연구단 -
 화학.재료
화학.재료


- 다기능성 단일 채널 흑린 기반 전자 소자 및 이의 제조 방법
- 등록번호 : 10-1963506
전자, 소자, 다기능, 반도체미래소재연구단 -
 화학.재료
화학.재료


- 이득조절이 가능한 그래핀-반도체 쇼트키 접합 광전소자
- 등록번호 : 10-1938934
그래핀, 반도체, 광전소자, 쇼트키미래소재연구단 -
 화학.재료
화학.재료


- 입체형 코일 구조를 갖는 자기장 발생 소자 및 그 제조 방법
- 등록번호 : 10-1898780
입체형, 코일, 자기장, 소자, 기판미래소재연구단 -
 화학.재료
화학.재료


- 원자 구조 해석 장치 및 방법
- 등록번호 : 10-1969242
투과, 전자, 현미경, 원자, 구조해석미래소재연구단 -
 화학.재료
화학.재료


- 에폭시 접착제용 첨가제 및 이를 포함하는 구조용 에폭시 접착제 조성물
- 등록번호 : 10-1893690
에폭시, 접착제, 첨가제미래소재연구단 -
 화학.재료
화학.재료


- 고전도성 폴리아닐린의 제조방법 및 이에 의해 제조된 고전도성 폴리아닐린
- 등록번호 : 10-1836204
아닐린, 폴리아닐린, 전도성미래소재연구단 -
 화학.재료
화학.재료


- 나트륨 이차전지용 Cu계 삽입금속 조성물 및 이를 이용한 세라믹-금속 간의 접합방법
- 등록번호 : 10-2004218
나트륨, 이차전지, 구리, 세라믹, 금속, 접합미래소재연구단 -
 화학.재료
화학.재료


- 높은 연신율 및 내충격성을 갖는 구조용 접착제 조성물
- 등록번호 : 10-1967043
접착제, 연신율, 내충격성, 에폭시미래소재연구단 -
 화학.재료
화학.재료


- 나노카본 복합 고성능 저가 탄소섬유 및 그 제조방법
- 등록번호 : 10-1689861
나노, 카본, 탄소섬유, 고성능미래소재연구단 -
 화학.재료
화학.재료


- 전기화학공정을 이용한 유기-무기 복합 반도체 소자 및 이의 제조방법
- 등록번호 : 10-1781985
반도체, 전기화학, 유기, 무기, 복합미래소재연구단 -
 화학.재료
화학.재료


- 열전 소자 및 그 제조 방법
- 등록번호 : 10-1783742
열전소자, 소자, 물질막미래소재연구단 -
 화학.재료
화학.재료


- 열전 반도체 소자 및 이를 포함한 열전 반도체 모듈
- 등록번호 : 10-1767908
열전소자, 반도체, 모듈미래소재연구단 -
 화학.재료
화학.재료


- 열전 소자 및 그 제조 방법
- 등록번호 : 10-1676322
열전소자, 소자미래소재연구단 -
 화학.재료
화학.재료


- 비공유 전자쌍을 갖는 원소가 담지된 금속유기골격체를 이용한 에너지 저장체용 전극재료, 이 를 포함하는 에너지 저장체 및 분석방법
- 등록번호 : 10-1829446
에너지, 저장, 전극미래소재연구단 -
 화학.재료
화학.재료


- 다공성 그래핀과 금속산화물 나노입자의 층상 구조체를 이용한 초고출력, 초장수명 리튬이차 전지 음극재료 및 그 제조방법
- 등록번호 : 10-1745449
다공성, 그래핀, 나노, 리튬, 이차전지, 고출력, 장수명, 음극미래소재연구단 -
 화학.재료
화학.재료


- 모체 금속-유기 골격체 내부에 나노 금속-유기 골격체가 포함된 금속-유기 복합 골격체, 이의 제조방법 및 이를 포함하는 기체 저장체
- 등록번호 : 10-1702652
금속, 유기, 골격체, 기체, 저장미래소재연구단 -
 화학.재료
화학.재료


- 나노결정 금속 유기 골격체를 템플레이트로 사용하는 다중금속 원소가 삽입된 직육면체형의 산화아연 나노 결정체의 제조 방법
- 등록번호 : 10-1595819
나고, 금속, 산화아연, 박막, 증착미래소재연구단 -
 화학.재료
화학.재료


- 가시광선하에서 물산화용 Co-Fe 2중층상 수산화물 광촉매 및 그 제조방법
- 등록번호 : 10-1579092
광촉매, 가시광선, 수산화물, 코발트, 이중, 층상미래소재연구단 -
 화학.재료
화학.재료


- 리튬 이차 전지용 양극활물질
- 등록번호 : 10-1666269
리튬, 전지, 이차전지, 배터리, 리튬배터리, 양극미래소재연구단 -
 화학.재료
화학.재료


- 리튬 복합 산화물 및 이의 제조 방법
- 등록번호 : 10-1605254
리튬, 산화물, 망간, 고용량, 배터리, 전지미래소재연구단 -
 화학.재료
화학.재료


- 공침법을 이용한 나트륨 이차전지용 양극활물질 전구체의 제조 방법 및 이에 의하여 제조된 나트륨 이차전지용 양극활물질 전구체
- 등록번호 : 10-1570125
이차전지, 양극, 양극활물질, 나트륨, 전구체미래소재연구단 -
 화학.재료
화학.재료


- 리튬황전지용 양극, 이를 포함하는 리튬황전지 및 이의 제조 방법
- 등록번호 : 10-1559124
리튬, 전지, 양극, 리튬전지, 배터리, 리튬배터리미래소재연구단 -
 화학.재료
화학.재료


- 이산화탄소 흡착제 및 이의 제조 방법
- 등록번호 : 10-1808554
이산화탄소, 흡착, 기공, 나노, 하이브리드미래소재연구단 -
 화학.재료
화학.재료


- 삼원 금속을 포함하는 유무기 하이브리드 나노세공체 및 이의 용도
- 등록번호 : 10-1776169
금속, 하이브리드, 나노, 세공체, 유기, 무기, 유무기미래소재연구단 -
 화학.재료
화학.재료


- 질소 선택적 흡착능을 갖는 유무기 하이브리드 나노세공체 및 이를 이용한 질소 함유 혼합기 체의 분리 방법
- 등록번호 : 10-1728809
질소, 선택, 흡착, 나노, 세공체, 질소, 기체, 분리미래소재연구단 -
 화학.재료
화학.재료


- 다공성 나노혼성 복합체, 이의 제조 방법, 및 이를 포함하는 이산화탄소 흡착제
- 등록번호 : 10-1639381
다공성, 나노, 복합체, 이산화탄소, 흡착, 흡착제미래소재연구단 -
 화학.재료
화학.재료


- 아연-글루타메이트 금속유기골격체를 촉매로 사용한 5원환 탄산염 화합물의 제조방법
- 등록번호 : 10-1635756
촉매, 탄산염, 아연, 글루타메이트미래소재연구단 -
 화학.재료
화학.재료


- 이황화몰리브덴 나노시트 및 이의 제조방법
- 등록번호 : 10-1623736
이황화몰리브덴, 나노, 시트미래소재연구단 -
 화학.재료
화학.재료


- 폴리실세스퀴옥산-표면개질된 유무기 나노세공체 및 이의 제조방법
- 등록번호 : 10-1606556
세공체, 나노, 표면, 개질미래소재연구단 -
 화학.재료
화학.재료


- 페로브스카이트 박막의 제조 방법
- 등록번호 : 10-1835233
페로브스카이트, 박막, 전구체미래소재연구단 -
 화학.재료
화학.재료


- 플라즈마 화학 기상 합성법을 활용한 탄소 기반 고 비표면적 나노 폼 소재 및 그 제조방법
- 등록번호 : 10-1802636
플라즈마, 기상, 합성, 탄소, 비표면적, 나노, 나노폼미래소재연구단 -
 화학.재료
화학.재료


- 나노 필라 제조방법
- 등록번호 : 10-1780549
나노, 필라, 니켈, 실리콘미래소재연구단 -
 화학.재료
화학.재료


- 단분산 금속 미세입자의 제조방법
- 등록번호 : 10-1699881
분산, 금속, 미세, 입자미래소재연구단 -
 화학.재료
화학.재료


- 금속 미세입자의 형상 제어 방법
- 등록번호 : 10-1699879
금속, 미세, 입자, 계면미래소재연구단 -
 화학.재료
화학.재료


- 티타늄금속기판 위에 다이아몬드 코팅층이 형성된 수처리용 구조재 및 그 제조 방법
- 등록번호 : 10-1695590
티타늄, 다이아몬드, 코팅, 수처리, 구조재미래소재연구단 -
 화학.재료
화학.재료


- 티타늄이 포함된 산화물 분산 강화 분산동 합금 및 그의 제조방법
- 등록번호 : 10-1693814
티타늄, 산화물, 분산, 구리합금, 동합금미래소재연구단 -
 화학.재료
화학.재료


- 전기장을 이용해 수직 정렬된 압전 나노 입자를 이용한 플렉서블 압전소자 및 그의 제조 방법
- 등록번호 : 10-1671673
압전, 나노, 플렉서블, 소자, 전기장미래소재연구단 -
 화학.재료
화학.재료


- 정전용량을 향상시킨 수퍼커패시터 및 그 제조방법
- 등록번호 : 10-1670597
정전용량, 커패시터, 그래핀, 전극미래소재연구단 -
 화학.재료
화학.재료


- 구조물의 균일 증착을 위하여 비틀림각을 연출하는 지그시스템
- 등록번호 : 10-1642188
증착, 비틀림각, 지그, 공구미래소재연구단 -
 화학.재료
화학.재료


- 아나타제상 이산화티탄 광촉매 코팅층의 형성방법
- 등록번호 : 10-1613704
이산화티탄, 광촉매, 코팅층미래소재연구단 -
 화학.재료
화학.재료


- 양각금형 가공을 위한 레이저 노광 방법
- 등록번호 : 10-1616069
포토레지스트, 금형, 양각금형미래소재연구단 -
 화학.재료
화학.재료


- Cr―V―C―N으로 이루어진 고 경도 내마모성 코팅 및 그 제조방법
- 등록번호 : 10-1600678
크롬, 고경도, 내마모성, 코팅미래소재연구단 -
 화학.재료
화학.재료


- 다층계면구조를 갖는 수처리용 DLC/Ti 전극 제조 방법
- 등록번호 : 10-1582446
다층, 계면, 수처리, DLC, 티타늄, 전극미래소재연구단 -
 화학.재료
화학.재료


- 다층계면구조를 갖는 수처리용 DLC/Ti 전극 제조 방법
- 등록번호 : 10-1573178
다층, 계면, 수처리, DLC, 티타늄, 전극미래소재연구단 -
 화학.재료
화학.재료


- 2차원 맥세인 박막의 제조방법, 이를 이용한 전자 소자의 제조 방법, 2차원 맥세인 박막을 포 함하는 전자 소자
- 등록번호 : 10-1807390
맥세인, 박막, 전자소자미래소재연구단 -
 화학.재료
화학.재료


- 금속-그래핀 이종 접합 금속 배선, 이의 형성방법 및 이를 포함하는 반도체 소자
- 등록번호 : 10-1795783
금속, 그래핀, 이종접합, 배선미래소재연구단 -
 화학.재료
화학.재료


- 다층 그래핀의 제조방법
- 등록번호 : 10-1751271
다층, 그래핀, 탄소, 합성미래소재연구단 -
 화학.재료
화학.재료


- 벤젠을 이용한 그래핀의 합성 방법
- 등록번호 : 10-1626776
그래핀, 합성, 벤젠미래소재연구단 -
 화학.재료
화학.재료


- 도너-억셉터 공액고분자 및 이를 포함하는 유기 전자 소자
- 등록번호 : 10-1610639
공액고분자, 유기전자소자미래소재연구단 -
 화학.재료
화학.재료


- 다층 그래핀의 제조방법
- 등록번호 : 10-1600782
다층, 그래핀, 탄소미래소재연구단 -
 화학.재료
화학.재료


- 압전 나노 소재의 압전 특성 측정 장치, 시스템 및 방법
- 등록번호 : 10-1642716
압전, 나노미래소재연구단 -
 화학.재료
화학.재료


- 성형 중합체 도입을 통한 수직 배향된 블록 공중합체 박막의 제조방법
- 등록번호 : 10-1756921
블록공중합체, 박막, 배향미래소재연구단 -
 화학.재료
화학.재료


- 이중 검출 반사 공초점 현미경 및 이를 사용하는 시편의 높이의 정보를 검출하는 방법
- 등록번호 : 10-1505745
이중검출, 공초점, 높이검출미래소재연구단 -
 화학.재료
화학.재료


- 금속을 포함하는 이온성 액체를 촉매로 사용한 글리세롤카보네이트의 제조방법
- 등록번호 : 10-1472322
촉매, 글리세롤카보네이트, 이온성미래소재연구단 -
 화학.재료
화학.재료


- TiAlN 벌크소재의 제조방법 및 마이크로 방전가공 방법
- 등록번호 : 10-1459196
Ti, 벌크소재, 방전미래소재연구단 -
 화학.재료
화학.재료


- 단결정 압전 섬유 포함 복합체 및 이를 포함하는 자기전기 복합재료 적층체
- 등록번호 : 10-1536973
압전, 자기전기, 복합체미래소재연구단 -
 의류.섬유.신발
의류.섬유.신발


- 3차원 프린터를 이용한 3차원 텍스타일 제조 시스템 및 이를 이용한 3차원 텍스타일 제조 방법
- 등록번호 : 10-1674546
3D프린터/3D텍스타일제조동아대학교 -
 의류.섬유.신발
의류.섬유.신발


- 광발열성 직물의 제조방법
- 등록번호 : 10-1463522
발열성직물동아대학교 -
 의류.섬유.신발
의류.섬유.신발


- 발열체가 내장된 신발 안창
- 등록번호 : 10-1513246
신발 안창동아대학교 -
 의류.섬유.신발
의류.섬유.신발


- 발광기능을 구비한 스마트 의류
- 등록번호 : 10-1381860
의류동아대학교 -
 의류.섬유.신발
의류.섬유.신발


- 다중공 필라멘트사 및 그 제조방법과 이를 이용하여 제조한 물품
- 등록번호 : 10-1298653
필라멘트사동아대학교 -
 생활.가정
생활.가정


- 쇼핑카트
- 등록번호 : 10-1735537
쇼핑카트동아대학교 -
 생활.가정
생활.가정


- 다기능 안전모 및 이를 이용한 작업 안전시스템
- 등록번호 : 10-1696751
안전모/작업안전동아대학교 -
 생활.가정
생활.가정


- 측단부 각도 조절이 가능한 파티션
- 등록번호 : 10-1739084
파티션동아대학교 -
 생활.가정
생활.가정


- 와위(臥位) 변경 장치
- 등록번호 : 10-1712818
와위 변경 장치동아대학교 -
 생활.가정
생활.가정


- 트렌스 폼 라이딩 재킷
- 등록번호 : 10-1726365
의류(라이딩 재킷)동아대학교 -
 생활.가정
생활.가정


- 손잡이 세정이 가능한 샤워헤드용 방향제어밸브
- 등록번호 : 10-1750453
방향제어밸브동아대학교 -
 생활.가정
생활.가정


- 경첩안전 장치
- 등록번호 : 10-1750254
안전장치동아대학교 -
 생활.가정
생활.가정


- 자동 스프링클러 및 그의 작동 방법
- 등록번호 : 10-1719202
스프링클러동아대학교 -
 생활.가정
생활.가정


- 압력 조절용 마개 및 그의 작동방법
- 등록번호 : 10-1689834
마개동아대학교 -
 생활.가정
생활.가정


- 안전 다리미
- 등록번호 : 10-1682383
다리미동아대학교 -
 생활.가정
생활.가정


- 소화기 안전핀 자동제거장치
- 등록번호 : 10-1610183
안전핀 제거장치/소화기동아대학교 -
 생활.가정
생활.가정


- 회전축을 가지는 회전 창문
- 등록번호 : 10-1580308
회전창문동아대학교 -
 생활.가정
생활.가정


- 범용 전원 어댑터 잭
- 등록번호 : 10-1602647
전원 어댑터 잭동아대학교 -
 생활.가정
생활.가정


- 도로의 곡선구간용 델리네이터
- 등록번호 : 10-1583319
델리네이터동아대학교 -
 생활.가정
생활.가정


- 안전 콘센트
- 등록번호 : 10-1571874
콘센트동아대학교 -
 생활.가정
생활.가정


- 선 자세로 물품을 수취할 수 있는 자판기
- 등록번호 : 10-1542900
자판기동아대학교 -
 생활.가정
생활.가정


- 스마트 연수기
- 등록번호 : 10-1638784
수처리/연수기동아대학교 -
 생활.가정
생활.가정


- 연결선의 길이조절이 가능한 마우스
- 등록번호 : 10-1535644
마우스동아대학교 -
 생활.가정
생활.가정


- 자전거의 안장 통합형 공기주입장치
- 등록번호 : 10-1523555
공기주입장치동아대학교 -
 생활.가정
생활.가정


- 동파방지용 수도꼭지
- 등록번호 : 10-1479743
수도꼭지동아대학교 -
 생활.가정
생활.가정


- 컵라면 뚜껑에 부착되는 화학반응 방식의 타이머
- 등록번호 : 10-1438337
타이머/컵라면 뚜껑 부착동아대학교 -
 생활.가정
생활.가정


- 형상기억합금을 이용한 화재방지기능이 구비된 선풍기
- 등록번호 : 10-1459966
선풍기동아대학교 -
 생활.가정
생활.가정


- 비트세트 일체형 전동 드라이버
- 등록번호 : 10-1512746
드라이버 공구동아대학교 -
 생활.가정
생활.가정


- 탈착식 우산커버
- 등록번호 : 10-1439062
우산커버동아대학교 -
 생활.가정
생활.가정


- 알껍질 제거장치
- 등록번호 : 10-1516494
알껍질 제거장치동아대학교 -
 생활.가정
생활.가정


- 벽걸이용 케이스
- 등록번호 : 10-1475159
벽걸이용 케이스동아대학교 -
 생활.가정
생활.가정


- 부착형 세제
- 등록번호 : 10-1494106
세제동아대학교 -
 생활.가정
생활.가정


- 턱 관절 교정을 위한 부착식 인지장치
- 등록번호 : 10-1452691
인지장치/턱관절교정동아대학교 -
 생활.가정
생활.가정


- 근적외선 다리미
- 등록번호 : 10-1442100
다리미동아대학교 -
 생활.가정
생활.가정


- 네트 스포츠의 경기장 구성을 위한 일체형 라인 패키지
- 등록번호 : 10-1499188
라인패키지동아대학교 -
 생활.가정
생활.가정


- 네트 스포츠의 경기장 구성을 위한 일체형 네트 패키지
- 등록번호 : 10-1463921
네트패키지동아대학교 -
 생활.가정
생활.가정


- 전동 칫솔
- 등록번호 : 10-1476366
전동칫솔동아대학교 -
 생활.가정
생활.가정


- 도어 스토퍼
- 등록번호 : 10-1439996
스토퍼동아대학교 -
 생활.가정
생활.가정


- 빗물 집수가 가능한 휴게용 벤치
- 등록번호 : 10-1354278
벤치동아대학교 -
 생활.가정
생활.가정


- 줄풀 거품 입욕제 조성물 및 그 제조방법
- 등록번호 : 10-1488376
입욕제 조성물동아대학교 -
 생활.가정
생활.가정


- 쿨링 시스템을 갖는 휴대 및 충전 겸용 거치대
- 등록번호 : 10-1463524
충전 거치대동아대학교 -
 생활.가정
생활.가정


- 불꽃수로 화력을 조절하는 가스레인지
- 등록번호 : 10-1413901
가스레인지동아대학교 -
 생활.가정
생활.가정


- 과전류 차단이 가능한 T자형 콘센트
- 등록번호 : 10-1346876
콘센트동아대학교 -
 생활.가정
생활.가정


- 다목적 드라이버 공구
- 등록번호 : 10-1395384
드라이버공구동아대학교 -
 생활.가정
생활.가정


- 유체검사 장치
- 등록번호 : 10-1489559
유체검사 장치동아대학교 -
 생활.가정
생활.가정


- 애완 동물용 사료통
- 등록번호 : 10-1341312
사료통동아대학교 -
 생활.가정
생활.가정


- 노트북 케이스
- 등록번호 : 10-1393893
노트북 케이스동아대학교 -
 생활.가정
생활.가정


- 수면보조기구
- 등록번호 : 10-1399687
수면보조기구동아대학교 -
 생활.가정
생활.가정


- 배터리 교체가 용이한 핸드폰 케이스
- 등록번호 : 10-1341295
핸드폰케이스동아대학교 -
 생활.가정
생활.가정


- 코골이 방지 베게
- 등록번호 : 10-1333221
베게동아대학교 -
 생활.가정
생활.가정


- 빗물 공급에 의한 만경식물 생육용 조경구조물
- 등록번호 : 10-1404854
조경구조물동아대학교 -
 생활.가정
생활.가정


- 살균손잡이
- 등록번호 : 10-1370608
살균손잡이동아대학교 -
 생활.가정
생활.가정


- 스마트폰용 탈부착 방식의 케이스 일체형 키버튼 구분 커버
- 등록번호 : 10-1301177
스마트폰용 커버동아대학교 -
 생활.가정
생활.가정


- 사이즈 가변형 신발
- 등록번호 : 10-1318868
신발동아대학교 -
 생활.가정
생활.가정


- 이동통신단말기의 배터리 충전장치
- 등록번호 : 10-1292195
배터리 충전장치동아대학교 -
 생활.가정
생활.가정


- 스마트폰 케이스
- 등록번호 : 10-1273981
스마트폰용 케이스동아대학교 -
 생활.가정
생활.가정


- 안전 콘센트
- 등록번호 : 10-1284216
콘센트동아대학교 -
 생활.가정
생활.가정


- 이중 스테이플러
- 등록번호 : 10-1346511
스테이플러동아대학교 -
 생활.가정
생활.가정


- 충전기능을 구비한 휴대폰 살균기
- 등록번호 : 10-1288176
살균기동아대학교 -
 생활.가정
생활.가정


- 높이 조절이 가능한 구두
- 등록번호 : 10-1288183
구두동아대학교 -
 생활.가정
생활.가정


- 절약형 용기
- 등록번호 : 10-1301780
베셀/용기동아대학교 -
 생활.가정
생활.가정


- 마이크 덮개 자동 포장기
- 등록번호 : 10-1276474
포장기동아대학교 -
 생활.가정
생활.가정


- 자동 안약 투여장치
- 등록번호 : 10-1258025
안약투여장치동아대학교 -
 생활.가정
생활.가정


- 치약 내장형 칫솔
- 등록번호 : 10-1263599
칫솔동아대학교 -
 생활.가정
생활.가정


- 고무줄이 구비된 기능성 반지
- 등록번호 : 10-1212414
반지동아대학교 -
 생활.가정
생활.가정


- 출수 온도-핸들 위치 연계에 따른 핸들 실시간 조작형 온도조절 수도꼭지 및 그를 이용한 출수 온도조절방법
- 등록번호 : 10-1273984
수도꼭지/온도조절동아대학교 -
 생활.가정
생활.가정


- 디옵터 안경용 입체 안경 어셈블리
- 등록번호 : 10-1180823
안경어셈블리동아대학교 -
 생활.가정
생활.가정


- 스마트 유리를 이용한 방범문 및 그 제어방법
- 등록번호 : 10-1184079
방범문동아대학교 -
 생활.가정
생활.가정


- 청소 신발
- 등록번호 : 10-1154862
신발동아대학교 -
 생활.가정
생활.가정


- 라면 조리장치
- 등록번호 : 10-1146643
라면조리장치동아대학교 -
 의료.바이오
의료.바이오


- 토종벌 유래 세카핀 펩티드
- 등록번호 : 10-1638863
미생물/효소/관련조성물동아대학교 -
 의료.바이오
의료.바이오


- 식물의 인산 흡수 효율을 증진시키는 OsMYB5P 유전자 및 이의 용도
- 등록번호 : 10-1707032
미생물/효소/관련조성물동아대학교 -
 의료.바이오
의료.바이오


- 수국 추출물을 함유하는 알코올성 신경정신질환 예방 및 치료용 조성물
- 등록번호 : 10-1719162
의약 조성물/치료용 제제동아대학교 -
 의료.바이오
의료.바이오


- 신규 셀룰로파가 속 미생물 및 그를 이용한 피레트로이드의 생물학적 분해 방법
- 등록번호 : 10-1743359
미생물/효소/관련조성물동아대학교 -
 의료.바이오
의료.바이오


- 폐암 치료용 의약 조성물, 정보 제공 및 스크리닝 방법
- 등록번호 : 10-1692246
의약 조성물/치료용 제제동아대학교 -
 의료.바이오
의료.바이오


- 마이크로불비퍼 속 유래 말토트리오스 생성용 아밀라아제 및 이를 이용한 말토트리오스 생산방법
- 등록번호 : 10-1706451
미생물/효소/관련조성물동아대학교 -
 의료.바이오
의료.바이오


- 의료용 다리 지지장치
- 등록번호 : 10-1607407
다리 지지장치동아대학교 -
 의료.바이오
의료.바이오


- TRAP1 유전자를 이용한 미토콘드리아 기능 장애 치료제 스크리닝 방법
- 등록번호 : 10-1648114
치료제 스크리닝 방법동아대학교 -
 의료.바이오
의료.바이오


- 곡류 시료 선별용 키트
- 등록번호 : 10-1710757
시료 선별 키트동아대학교 -
 의료.바이오
의료.바이오


- 과산화수소를 포함하는 푸자리움 푸지쿠로이의 선택배지 및 이의 용도
- 등록번호 : 10-1647557
미생물/효소/관련조성물동아대학교 -
 의료.바이오
의료.바이오


- 이종 간에 작용하는 유전자 마커 디자인을 위한 CSGM 디자이너 플랫폼
- 등록번호 : 10-1599922
디자이너 플랫폼동아대학교 -
 의료.바이오
의료.바이오


- 식물의 철 이용 능력을 향상시키는 벼 유래 OsIT 유전자 및 이의 용도
- 등록번호 : 10-1648719
미생물/효소/관련조성물동아대학교 -
 의료.바이오
의료.바이오


- 항진균 및 살충용 토종벌 유래 ICK 펩타이드
- 등록번호 : 10-1676917
미생물/효소/관련조성물동아대학교 -
 의료.바이오
의료.바이오


- 나노-마이크로 하이브리드 섬유 기반의 미성숙 수지상세포 배양방법 및 분석방법
- 등록번호 : 10-1477106
미생물/효소/관련조성물동아대학교 -
 의료.바이오
의료.바이오


- ABF3 유전자로 형질전환된 가뭄 저항성 콩 식물체 및 이의 제조 방법
- 등록번호 : 10-1587019
콩 식물체동아대학교 -
 의료.바이오
의료.바이오


- 오동나무로부터 분리된 디플라콘계 플라보노이드 화합물을 유효성분으로 함유하는 방사선 방호용 조성물
- 등록번호 : 10-1612612
방사선 방호용 조성물동아대학교 -
 의료.바이오
의료.바이오


- SLC6A3 유전자의 다형성 소위성과 이를 이용한 DNA 타이핑 키트 및 상기 유전자 관련 질병의 진단키트
- 등록번호 : 10-1588119
진단키트동아대학교 -
 의료.바이오
의료.바이오


- 교체가능한 자가결찰 치아교정장치
- 등록번호 : 10-1541126
치아교정장치동아대학교 -
 의료.바이오
의료.바이오


- 손상된 DNA의 회복 속도 비교를 위한 정보 제공 방법
- 등록번호 : 10-1542324
DNA 회복 속도 비교/정보 제공 방법동아대학교 -
 의료.바이오
의료.바이오


- 3차원 구조의 다단 세포배양 구조체, 이를 포함하는 에세이칩 및 에세이칩을 이용한 세포 분석방법
- 등록번호 : 10-1458425
미생물/효소/관련조성물동아대학교 -
 의료.바이오
의료.바이오


- 방광암 재발 진단 마커
- 등록번호 : 10-1683961
진단 마커동아대학교 -
 의료.바이오
의료.바이오


- 미토콘드리아성 복합체Ⅰ저해제를 유효성분으로 함유하는 증식성 유리체망막병증의 예방 또는 치료용 약학적 조성물
- 등록번호 : 10-1587483
치료용 조성물동아대학교 -
 의료.바이오
의료.바이오


- 나노-마이크로 하이브리드섬유 기반 세포배양 구조체 및 이를 포함하는 에세이칩
- 등록번호 : 10-1453796
에세이칩동아대학교 -
 의료.바이오
의료.바이오


- 나노섬유기반 세포배양 나노구조체 및 이를 포함하는 에세이 칩
- 등록번호 : 10-1446687
에세이칩동아대학교 -
 의료.바이오
의료.바이오


- 당귀 발효물을 유효성분으로 함유하는 간질환의 예방 또는 치료용 약학 조성물 및 건강식품 조성물
- 등록번호 : 10-1569740
식품동아대학교 -
 의료.바이오
의료.바이오


- 산왕거미 유래 메이져 엠풀레이트 스피드로인 단백질을 유효성분으로 포함하는 당뇨병 및 당뇨합병증 예방 또는 치료용 약제학적 조성물
- 등록번호 : 10-1597006
치료용 조성물동아대학교 -
 의료.바이오
의료.바이오


- 제아라레논 분해 활성을 가지는 아그로마이세스 속 M15 균주 및 이의 용도
- 등록번호 : 10-1494624
균주동아대학교 -
 의료.바이오
의료.바이오


- 식물의 개화조절인자인 CmSOC1 신규 유전자 및 이를 이용한 식물의 개화시기 조절 방법
- 등록번호 : 10-1548052
미생물/효소/관련조성물동아대학교 -
 의료.바이오
의료.바이오


- 콩 모자이크 바이러스에 대한 내성이 증진된 콩 형질전환 식물체 및 그 제조방법
- 등록번호 : 10-1552140
미생물/효소/관련조성물동아대학교 -
 의료.바이오
의료.바이오


- 벼 유래의 잎 발달 관련 유전자 및 이의 용도
- 등록번호 : 10-1546727
미생물/효소/관련조성물동아대학교 -
 의료.바이오
의료.바이오


- 식물의 인산 흡수 효율을 증진시키는 OgPT 유전자 및 이의 용도
- 등록번호 : 10-1546728
미생물/효소/관련조성물동아대학교 -
 의료.바이오
의료.바이오


- 신균주인 바실러스 푸밀러스 BD129 균주 및 이의 용도
- 등록번호 : 10-1597876
균주동아대학교 -
 의료.바이오
의료.바이오


- 식물의 인산 흡수 효율을 증진시키는 OsMYB4P 유전자 및 이의 용도
- 등록번호 : 10-1533000
미생물/효소/관련조성물동아대학교 -
 의료.바이오
의료.바이오


- 밀리타리스 동충하초와 그 추출물을 함유한 기능성 장류의 제조방법
- 등록번호 : 10-1567635
식품동아대학교 -
 의료.바이오
의료.바이오


- 간 압박지혈기구
- 등록번호 : 10-1437786
의료기구동아대학교 -
 의료.바이오
의료.바이오


- SCK/SLI 유전자의 미니새틀라이트를 이용한 영장류 또는 영장류 개체 식별용 미니새틀라이트 마커 조성물
- 등록번호 : 10-1545935
마커 조성물동아대학교 -
 의료.바이오
의료.바이오


- 오사게 오렌지로부터 분리된 오사진 또는 포미페린을 유효성분으로 함유하는 당뇨 예방 또는 치료용 약학 조성물 및 건강식품 조성물
- 등록번호 : 10-1530540
치료용 조성물동아대학교 -
 의료.바이오
의료.바이오


- 항균 및 항진균 활성을 갖는 신규 폴리펩티드
- 등록번호 : 10-1481902
미생물/효소/관련조성물동아대학교 -
 의료.바이오
의료.바이오


- 비장 지혈용 집게 타입의 의료 기구
- 등록번호 : 10-1435135
의료기구동아대학교 -
 의료.바이오
의료.바이오


- 피부 온도 연속 측정기
- 등록번호 : 10-1474121
피부 온도 측정기동아대학교 -
 의료.바이오
의료.바이오


- 시린진과 코니페린 함량이 증가된 형질전환 콩 식물체의 제조 방법 및 그에 따른 콩 식물체
- 등록번호 : 10-1399944
미생물/효소/관련조성물동아대학교 -
 의료.바이오
의료.바이오


- 대두 유래의 GmC3H9 유전자 및 이의 용도
- 등록번호 : 10-1376961
미생물/효소/관련조성물동아대학교 -
 의료.바이오
의료.바이오


- 발효 현미를 이용한 쌀 가공식품 및 이의 제조방법
- 등록번호 : 10-1429366
식품동아대학교 -
 의료.바이오
의료.바이오


- 황칠나무로부터 분리한 올레이폴리오사이드 A를 유효성분으로 포함하는 항암용 약학 조성물
- 등록번호 : 10-1426258
약제조성물동아대학교 -
 의료.바이오
의료.바이오


- 한약재로부터 분리한 신규한 JNP3 화합물 및 이를 유효성분으로 포함하는 항암용 약학 조성물
- 등록번호 : 10-1484526
약제조성물동아대학교 -
 의료.바이오
의료.바이오


- 시린진 생산이 증가된 형질전환 식물체의 제조 방법 및 그에 따른 식물체
- 등록번호 : 10-1399946
미생물/효소/관련조성물동아대학교 -
 의료.바이오
의료.바이오


- 플라스민 및 엘라스타아제 저해 활성을 갖는 산왕거미 유래의 쿠니츠 타입 세린 프로테아제 저해 단백질 및 이를 유효성분으로 포함하는 염증 억제 및 항섬유소용해용 조성물
- 등록번호 : 10-1437408
미생물/효소/관련조성물동아대학교 -
 의료.바이오
의료.바이오


- 내염성 퍼클로레이트 또는 나이트레이트 제거 미생물의 농화배양방법
- 등록번호 : 10-1432076
미생물/효소/관련조성물동아대학교 -
 의료.바이오
의료.바이오


- 식물체 내의 시린진 합성을 증가시키는 재조합 당전이 효소 단백질 코딩 유전자 및 이의 용도
- 등록번호 : 10-1399941
미생물/효소/관련조성물동아대학교 -
 의료.바이오
의료.바이오


- 토양 메타게놈 유래의 에스터라제 ELP104 유전자 및 이의 용도
- 등록번호 : 10-1347110
미생물/효소/관련조성물동아대학교 -
 의료.바이오
의료.바이오


- 토양 메타게놈 유래의 에스터라제 EST33 유전자 및 이의 용도
- 등록번호 : 10-1347108
미생물/효소/관련조성물동아대학교 -
 의료.바이오
의료.바이오


- 토양 메타게놈 유래의 에스터라제 ELP96 유전자 및 이의 용도
- 등록번호 : 10-1356478
미생물/효소/관련조성물동아대학교 -
 의료.바이오
의료.바이오

- 토양 메타게놈 유래의 에스터라제 ELP86 유전자 및 이의 용도
- 등록번호 : 10-1347111
미생물/효소/관련조성물동아대학교 -
 의료.바이오
의료.바이오


- 당뇨병 개선 효과능이 있는 탱자 발효 조성물
- 등록번호 : 10-1626642
탱자 발효 조성물동아대학교 -
 의료.바이오
의료.바이오


- 회전효소 Ⅰ 저해제 및 지방산 합성효소 저해제를 포함하는 항암제
- 등록번호 : 10-1460200
항암제동아대학교 -
 의료.바이오
의료.바이오


- 연속적인 올리고뉴클리오타이드 프라이머를 이용한 유전자의 합성 방법
- 등록번호 : 10-1406153
미생물/효소/관련조성물동아대학교 -
 의료.바이오
의료.바이오


- 토양 메타게놈 유래의 WES 유전자 및 이의 용도
- 등록번호 : 10-1399945
미생물/효소/관련조성물동아대학교 -
 의료.바이오
의료.바이오


- 태반 양막 유래 중간엽 줄기세포의 배양방법 및 말초 동맥 질환 치료법 및 조성물
- 등록번호 : 10-1382566
치료용 조성물동아대학교 -
 의료.바이오
의료.바이오


- 갯무 유래의 RsSIP1 유전자 및 이의 용도
- 등록번호 : 10-1350228
미생물/효소/관련조성물동아대학교 -
 의료.바이오
의료.바이오


- 갯무 유래의 RsERF1 유전자 및 이의 용도
- 등록번호 : 10-1350225
미생물/효소/관련조성물동아대학교 -
 의료.바이오
의료.바이오


- 에케베리아 대량 생산을 위한 캘러스 유도 및 재분화용 배지 조성물
- 등록번호 : 10-1286719
미생물/효소/관련조성물동아대학교 -
 의료.바이오
의료.바이오


- 산왕거미 유래 메이저 엠풀레이트 스피드로인 단백질의 반복적인 C-말단 영역의 폴리펩티드 서열 및 이를 코딩하는 염기서열
- 등록번호 : 10-1494711
미생물/효소/관련조성물동아대학교 -
 의료.바이오
의료.바이오


- 항섬유소용해 기능을 가진 호박벌 독액의 쿠니츠 타입 세린 프로테아제 저해 폴리펩티드 및 이를 코딩하는 염기서열
- 등록번호 : 10-1391988
미생물/효소/관련조성물동아대학교 -
 의료.바이오
의료.바이오


- 미토콘드리아 게놈의 전사조절에 관여하는 유전자의 활성을 스크리닝하는 방법
- 등록번호 : 10-1298140
미생물/효소/관련조성물동아대학교 -
 의료.바이오
의료.바이오


- 유비퀴틴 결합 효소 E2 또는 이를 코딩하는 유전자를 유효성분으로 포함하는 스트레스에 대한 저항성 증가용 조성물
- 등록번호 : 10-1342437
미생물/효소/관련조성물동아대학교 -
 의료.바이오
의료.바이오


- 식물의 카로티노이드 함량을 증가시키는 PAC 다중 발현 유전자 및 이의 용도
- 등록번호 : 10-1270232
미생물/효소/관련조성물동아대학교 -
 의료.바이오
의료.바이오


- 식물의 염 스트레스에 대한 저항성을 증가시키는 AtSZF2 유전자 및 이의 용도
- 등록번호 : 10-1270231
미생물/효소/관련조성물동아대학교 -
 의료.바이오
의료.바이오


- 스트레스 저항성을 증진시키는 유전자 및 이의 용도
- 등록번호 : 10-1298130
미생물/효소/관련조성물동아대학교 -
 의료.바이오
의료.바이오


- 밀리타리스 동충하초 추출물 제조방법 및 이에 따라 제조된 밀리타리스 동충하초 추출물을 포함하는 건강보조식품
- 등록번호 : 10-1275375
식품동아대학교 -
 의료.바이오
의료.바이오


- Sir-FOXO 신호전달체계 활성인자를 포함하는 퇴행성 신경질환 치료용 조성물
- 등록번호 : 10-1466700
치료용 조성물동아대학교 -
 의료.바이오
의료.바이오


- 황칠나무로부터 분리한 덴드로파녹사이드를 유효성분으로 포함하는 당뇨병 예방 또는 치료용 조성물
- 등록번호 : 10-1406138
치료용 조성물동아대학교 -
 의료.바이오
의료.바이오


- 레스베라트롤의 유사체인 HS-1793 또는 이의 약학적으로 허용가능한 염을 유효성분으로 하는 전립선 암 치료용 약학적 조성물
- 등록번호 : 10-1274731
약제조성물동아대학교 -
 의료.바이오
의료.바이오


- 인산결핍조건에서 발현되는 벼 유비퀴틴 결합 효소 유전자 (OsUPS)
- 등록번호 : 10-1244250
유전자동아대학교 -
 의료.바이오
의료.바이오


- 유효성분으로 치커리 뿌리 추출물을 함유하는 지방간의 예방 또는 치료용 조성물
- 등록번호 : 10-1258833
치료용 조성물동아대학교 -
 의료.바이오
의료.바이오


- 국화 형질전환체 및 이의 제조방법
- 등록번호 : 10-1200898
국화 형질전환체동아대학교 -
 의료.바이오
의료.바이오


- 아포지단백질 A1 및 수지상 세포를 유효성분으로 포함하는 암의 예방 또는 치료용 약학적 조성물
- 등록번호 : 10-1169331
약제조성물동아대학교 -
 의료.바이오
의료.바이오


- BORIS 유전자의 다형성 소위성을 이용한 DNA 타이핑 키트 및 암 진단용 키트
- 등록번호 : 10-1164870
진단키트동아대학교 -
 의료.바이오
의료.바이오


- 말초 혈액 수지상 세포 아형의 분석을 통한 암의 진단방법
- 등록번호 : 10-1236983
암 진단방법동아대학교 -
 의료.바이오
의료.바이오


- MUC8 유전자의 다형성 소위성을 이용한 MUC8 유전자 관련 질병의 진단용 키트
- 등록번호 : 10-1164873
진단키트동아대학교 -
 의료.바이오
의료.바이오


- MUC4 유전자의 다형성 소위성을 이용한 DNA 타이핑 키트 및 MUC4유전자 관련 질병의 진단용 키트
- 등록번호 : 10-1169329
진단키트동아대학교 -
 의료.바이오
의료.바이오


- MUC2 유전자의 다형성 소위성과 이를 이용한 DNA 타이핑 키트 및 암 진단 키트
- 등록번호 : 10-1183084
진단키트동아대학교 -
 화학.재료
화학.재료


- 에너지 절감형 원유정제장치 및 이 장치를 이용한 원유정제방법
- 등록번호 : 10-1673491
원유정제동아대학교 -
 화학.재료
화학.재료


- 추출공정의 부하를 감소시킨 방향족 화합물 분리장치 및 이 장치를 이용한 방향족 화합물의 분리방법
- 등록번호 : 10-1674660
화합물 분리동아대학교 -
 화학.재료
화학.재료


- 나프타 개질 혼합물로부터의 벤젠 분리장치 및 이 장치를 이용한 벤젠 분리방법
- 등록번호 : 10-1674655
벤젠 분리동아대학교 -
 화학.재료
화학.재료


- 그래프트형 광감응성 수화겔, 이를 포함하는 엑츄에이터 및 이의 제조방법
- 등록번호 : 10-1682910
액츄에이터/광감응성 수화겔동아대학교 -
 화학.재료
화학.재료


- 응집제가 함유된 미세광미로부터 중금속 제거방법
- 등록번호 : 10-1562803
중금속 제거방법동아대학교 -
 화학.재료
화학.재료


- 미세유체 장치를 이용한 고분자 섬유의 제조방법 및 이를 이용하여 제조된 고분자 섬유
- 등록번호 : 10-1693598
고분자섬유/미세유체장치동아대학교 -
 화학.재료
화학.재료


- 양극활물질-메조기공성 탄소소재 나노복합체의 제조방법, 이에 따라 제조된 양극활물질-메조기공성 탄소소재 나노복합체 및 상기 나노복합체를 포함하는 리튬이차전지
- 등록번호 : 10-1672843
리튬이차전지/나노복합체동아대학교 -
 화학.재료
화학.재료


- 자력선별과 폐식용유를 이용한 바텀애쉬에서 미연탄소를 회수하는 방법
- 등록번호 : 10-1565906
탄소회수동아대학교 -
 화학.재료
화학.재료


- 자성 나노입자를 포함하고 표적지향 리간드가 결합된 자극감응성 수화겔 나노입자
- 등록번호 : 10-1671331
수화겔 나노입자동아대학교 -
 화학.재료
화학.재료


- 일체형 분리벽 증류탑을 이용한 해상 액화천연가스 분별증류장치
- 등록번호 : 10-1592498
분별증류장치동아대학교 -
 화학.재료
화학.재료


- 카르복실산을 이용하여 탄소 코팅층을 형성하는 리튬이차전지용 양극활물질의 제조방법, 이에 따라 제조된 양극활물질 및 상기 양극활물질을 포함하는 리튬이차전지
- 등록번호 : 10-1685460
양극활물질/리튬이차전지동아대학교 -
 화학.재료
화학.재료


- 수증기 차단성 투명 고분자 복합필름
- 등록번호 : 10-1543260
투명필름/수증기차단동아대학교 -
 화학.재료
화학.재료


- 열교환 분리벽형 증류탑을 이용한 해상 액화천연가스 분별증류장치
- 등록번호 : 10-1550046
분별증류장치동아대학교 -
 화학.재료
화학.재료


- 산화그래핀의 광열전환 효과를 이용한 광감응성 수화겔 및 이의 제조방법
- 등록번호 : 10-1537372
광감음성 수화겔동아대학교 -
 화학.재료
화학.재료


- 상대함수율에 따른 전기비저항 측정 장치
- 등록번호 : 10-1527805
전기비저항 측정 장치동아대학교 -
 화학.재료
화학.재료


- 전도성 분말의 제조방법 및 전도성 분말을 이용한 전도성 페이스트
- 등록번호 : 10-1499141
전도성 페이스트동아대학교 -
 화학.재료
화학.재료


- 분리벽형 증류탑을 이용한 해상 액화천연가스 분별증류장치
- 등록번호 : 10-1425650
분별증류장치동아대학교 -
 화학.재료
화학.재료


- 망상구조를 가지는 수화겔을 이용한 양극활물질의 제조방법 및 탄소층이 코팅된 양극활물질
- 등록번호 : 10-1499196
양극활물질동아대학교 -
 화학.재료
화학.재료


- 퍼클로레이트와 나이트레이트를 분해하는 황산화미생물의 농화배양 및 농화배양미생물을 이용한 퍼클로레이트와 나이트레이트의 연속처리장치
- 등록번호 : 10-1439728
수처리/미생물이용동아대학교 -
 화학.재료
화학.재료


- 내부에 그래핀 네트워크가 형성된 나노입자-그래핀-탄소 복합체, 이의 제조방법 및 이의 응용
- 등록번호 : 10-1478160
탄소 복합체/그래핀동아대학교 -
 화학.재료
화학.재료


- 열교환형 수평 증류관이 구비된 무환류 분별증류 장치
- 등록번호 : 10-1335341
분별증류장치동아대학교 -
 화학.재료
화학.재료


- 셀룰로오스 필름의 제조방법 및 이 방법에 의해 제조된 셀룰로오스 필름
- 등록번호 : 10-1223952
셀룰로오스 필름동아대학교 -
 화학.재료
화학.재료


- 판상 산화 제1주석의 형성방법
- 등록번호 : 10-1269111
산화주석 플레이트동아대학교 -
 화학.재료
화학.재료


- 내부 열교환 증류탑이 구비된 2 성분 분별증류장치
- 등록번호 : 10-1268285
분별증류장치동아대학교 -
 화학.재료
화학.재료


- 고내구성 및 고내식성 철강소재 기계부품의 표면개질 처리방법
- 등록번호 : 10-1269572
철강부품동아대학교 -
 화학.재료
화학.재료


- 내부 열교환 증류탑이 구비된 4 성분 분별증류장치
- 등록번호 : 10-1210401
분별증류장치동아대학교 -
 화학.재료
화학.재료


- 기체 저장매체의 열분석 방법 및 기체 저장매체의 분석장치
- 등록번호 : 10-1234854
열분석동아대학교 -
 화학.재료
화학.재료


- 항균 코팅용액과 그의 제조방법 및 그를 이용한 항균 코팅방법
- 등록번호 : 10-1140841
향균코팅용액/향균코팅방법동아대학교 -
 화학.재료
화학.재료


- 전분 또는 식물 생체 바이오매스로부터 하이드록시메틸푸르푸랄을 생산하는 방법
- 등록번호 : 10-1247639
하이드록시메틸푸르푸랄 생산동아대학교 -
 화학.재료
화학.재료


- 기체 차단성 투명 고분자 필름
- 등록번호 : 10-1209293
고분자 필름동아대학교 -
 화학.재료
화학.재료


- 내부 열교환 증류탑이 구비된 3 성분 분별증류장치
- 등록번호 : 10-1173907
분별증류장치동아대학교 -
 화학.재료
화학.재료


- 수크로스로부터 하이드록시메틸푸르푸랄의 합성방법
- 등록번호 : 10-1139939
하이드록시메틸푸르푸랄 생산동아대학교 -
 정보통신.S/W
정보통신.S/W


- 지반변형 억제 시스템에서의 관정의 최적화 설계 방법
- 등록번호 : 10-1706280
관정 최적설계동아대학교 -
 정보통신.S/W
정보통신.S/W


- 단위 특징형상 단순화를 이용한 CAD 모델의 특징형상기반단순화 방법 및 시스템
- 등록번호 : 10-1640913
CAD 모델 수정 시스템동아대학교 -
 정보통신.S/W
정보통신.S/W


- NETCONF 프로토콜의 콘텐츠 계층 개선을 위한 장치 및 방법
- 등록번호 : 10-1674543
프로토콜동아대학교 -
 정보통신.S/W
정보통신.S/W


- 디지털 오일필드에서 인공신경망을 이용한 생산량 제어방법
- 등록번호 : 10-1706245
생산량 제어동아대학교 -
 정보통신.S/W
정보통신.S/W


- NETCONF 프로토콜의 RPC 계층 개선을 위한 장치 및 방법
- 등록번호 : 10-1655966
RFID 시스템동아대학교 -
 정보통신.S/W
정보통신.S/W


- 지하저수지 주입 양수 계통의 최적 설계 방법
- 등록번호 : 10-1658730
양수 계통 최적 설계동아대학교 -
 정보통신.S/W
정보통신.S/W


- 위키피디아의 언어자원과 병렬 코퍼스를 이용한 교차언어 검색기의 질의어 번역 시스템 및 방법
- 등록번호 : 10-1616031
번역시스템동아대학교 -
 정보통신.S/W
정보통신.S/W


- 대화시스템에서 사용자 발화의 정보 분류를 위한 자질 가중치 산출 장치 및 방법
- 등록번호 : 10-1565143
음성분석동아대학교 -
 정보통신.S/W
정보통신.S/W


- 자연어 질의 기반의 수학식 검색 시스템 및 방법
- 등록번호 : 10-1567904
수학식 검색 시스템동아대학교 -
 정보통신.S/W
정보통신.S/W


- 모바일 대화 시스템의 언어 인식 모듈을 위한 동시 인식 장치 및 방법
- 등록번호 : 10-1559576
언어인식/모바일 대화동아대학교 -
 정보통신.S/W
정보통신.S/W


- 위치 정보를 구비한 컨텐츠 제공 시스템 및 방법그리고 그 위치 정보 제공 장치
- 등록번호 : 10-1648026
위치정보제공동아대학교 -
 정보통신.S/W
정보통신.S/W


- 효율적인 데이터 수집을 위한 미들웨어 장치 그리고 미들웨어 장치의 효율적인 데이터 수집 방법
- 등록번호 : 10-1602645
미들웨어장치동아대학교 -
 정보통신.S/W
정보통신.S/W


- 단계적 볼륨 분해를 이용한 CAD 모델 수정 시스템 및 방법
- 등록번호 : 10-1439997
CAD모델 수정 시스템동아대학교 -
 정보통신.S/W
정보통신.S/W


- 센서 응용 프로그램 테스트 장치 및 방법
- 등록번호 : 10-1468394
테스트 장치동아대학교 -
 정보통신.S/W
정보통신.S/W


- 지능형 생산정 위치 선정 전산 시스템 및 이를 이용한생산정 위치 선정 방법
- 등록번호 : 10-1474874
생산정 위치 선정 방법동아대학교 -
 정보통신.S/W
정보통신.S/W


- 힐버트 및 제곱근 혼합 방식을 이용한 디지털 위상천이장치 및 방법
- 등록번호 : 10-1380248
위상천이 장치동아대학교 -
 정보통신.S/W
정보통신.S/W


- 상황-적응적 통신 거리를 가지는 RFID 통신 방법 및RFID 시스템
- 등록번호 : 10-1355936
RFID 시스템동아대학교 -
 정보통신.S/W
정보통신.S/W


- 음영지역에서의 정보 수집을 위한 통신 방법 및 시스템
- 등록번호 : 10-1158344
컨테이너, 선박 등의 음영지역에서의 통신 장치동아대학교 -
 정보통신.S/W
정보통신.S/W


- 실시간 위치 추적 시스템의 데이터 통신 방법
- 등록번호 : 10-1335498
위치추적/데이터통신동아대학교 -
 정보통신.S/W
정보통신.S/W


- 위치 정보 수집 서버 및 그의 위치 정보 관리 방법
- 등록번호 : 10-1318903
위치정보 수집관리동아대학교 -
 정보통신.S/W
정보통신.S/W


- IP 핵심기능을 수용하는 액티브 IP-RFID 시스템,장치 및 방법
- 등록번호 : 10-1338960
RFID 시스템동아대학교 -
 정보통신.S/W
정보통신.S/W


- IP-RFID를 이용한 유실 어구 위치 확인 시스템, 장치 및 방법
- 등록번호 : 10-1191136
RFID 시스템/유실 어구 위치확인/위치기반 서비스동아대학교 -
 정보통신.S/W
정보통신.S/W


- 음영지역 환경에서 멀티홉을 이용한 점진적 위치인식 시스템 및 그 방법
- 등록번호 : 10-1270573
음영지역의 위치인식 시스템동아대학교 -
 정보통신.S/W
정보통신.S/W


- 노드 관리 시스템 및 이를 기반으로 하는 네트워크 가입 처리 방법, 데이터 전송 방법, 노드 이탈 처리 방법, 경로 변경 처리 방법 및 경로 광고 수신 처리 방법
- 등록번호 : 10-1270068
컨테이너 통신 장치, 네트워크 노드 관리 시스템동아대학교 -
 정보통신.S/W
정보통신.S/W


- 도난 차량 회수 지원 방법과 시스템, 및 이를 지원하는 장치
- 등록번호 : 10-1214365
도난 차량 위치 추적, 치안 서비스동아대학교 -
 정보통신.S/W
정보통신.S/W


- 해수 침투 모니터링 장치 및 방법
- 등록번호 : 10-1190325
해수 침투 모니터링동아대학교 -
 정보통신.S/W
정보통신.S/W


- 무선 네트워크를 이용한 RIGC 원격제어 시스템
- 등록번호 : 10-1243882
원격제어/무선네트워크동아대학교 -
 정보통신.S/W
정보통신.S/W


- 조합 지문 인식을 이용한 무선 제어 시스템 및 방법
- 등록번호 : 10-1160452
지문인식/무선제어동아대학교 -
 정보통신.S/W
정보통신.S/W


- IP통신 기능을 가진 RFID 태그가 부착된 구조장비
- 등록번호 : 10-1160451
RFID시스템/구조장비동아대학교 -
 전자.전기
전자.전기


- 스마트 기기와 오토레벨 장비의 결합을 통한 측량장치
- 등록번호 : 10-1687251
측량장치동아대학교 -
 전자.전기
전자.전기


- 압전 블록 구조체 및 그 제조 방법과 이를 이용한에너지 하베스팅 시스템
- 등록번호 : 10-1722937
압전 블록 구조/에너지 하베스팅동아대학교 -
 전자.전기
전자.전기


- 부착형 압전소자의 어드미턴스 신호를 이용한단순보 공진 예측 기법
- 등록번호 : 10-1691458
공진 예측 기법/압전소자동아대학교 -
 전자.전기
전자.전기


- 영상데이터를 이용한 패턴정보 추출방법
- 등록번호 : 10-1707625
영상처리동아대학교 -
 전자.전기
전자.전기


- 휴머노이드 로봇의 자세 제어 장치 및 방법
- 등록번호 : 10-1740249
로봇/자세 제어 장치동아대학교 -
 전자.전기
전자.전기


- 점감 기법을 채택하는 채널 스케일링 기반의 안테나 선택 장치 및 방법
- 등록번호 : 10-1644562
안테나 선택장치동아대학교 -
 전자.전기
전자.전기


- 픽셀 방향정보를 사용한 영상정보 내 패턴정보영역 검출방법
- 등록번호 : 10-1689705
영상처리동아대학교 -
 전자.전기
전자.전기


- 수준측량 어플을 탑재한 스마트폰
- 등록번호 : 10-1655013
수준측량/스마트기기동아대학교 -
 전자.전기
전자.전기


- 스마트 기기를 이용한 오토 레벨 수준 측량장치
- 등록번호 : 10-1653484
수준측량/스마트기기동아대학교 -
 전자.전기
전자.전기


- 스플리터가 형성된 뱅크구조를 이용한 유기 박막트랜지스터의 제조방법
- 등록번호 : 10-1663194
박막 트랜지스터동아대학교 -
 전자.전기
전자.전기


- 초음파 세척기의 발진 출력 제어 방법 및 그 장치
- 등록번호 : 10-1704488
초음파 세척기동아대학교 -
 전자.전기
전자.전기


- 저속 모터를 이용한 세탁기의 구동장치 및 이를 이용한세탁기의 구동 방법
- 등록번호 : 10-1628292
세탁기동아대학교 -
 전자.전기
전자.전기


- 세탁기의 구동장치 및 이를 이용한 세탁기의 구동 방법
- 등록번호 : 10-1644561
세탁기동아대학교 -
 전자.전기
전자.전기


- 표면고정에너지 제어가 가능한 액정표시장치 및 그 제조 방법 그리고 이를 위한 제조 장치
- 등록번호 : 10-1666550
액정표시장치 제조동아대학교 -
 전자.전기
전자.전기


- 낮은 셀 갭을 갖는 2D/3D 스위처블 액정렌즈 및그의 제조 방법
- 등록번호 : 10-1588389
액정렌즈동아대학교 -
 전자.전기
전자.전기


- 깊이정보를 사용한 바닥영역 처리방법과 이를 위한 처리장치 및 프로그램을 기록한 컴퓨터 판독 가능 기록 매체
- 등록번호 : 10-1566448
바닥영역 처리/데이터 처리동아대학교 -
 전자.전기
전자.전기


- 인간과 유사한 이족 보행을 위한 인간형 로봇의 하지 관절궤적 생성 방법
- 등록번호 : 10-1607573
로봇/하지 관절궤적 생성동아대학교 -
 전자.전기
전자.전기


- 4-도메인 수직정렬 액정 모드의 그레이 레벨 개선을 위한광학보상구조
- 등록번호 : 10-1441075
광학보상동아대학교 -
 전자.전기
전자.전기


- 2D-3D 스위처블 액정렌즈의 설계방법
- 등록번호 : 10-1307774
액정렌즈동아대학교 -
 전자.전기
전자.전기


- 접착시트를 포함하는 유기발광다이오드 소자 및이의 형성 방법
- 등록번호 : 10-1380823
OLED동아대학교 -
 전자.전기
전자.전기


- 초광대역 다중 사용자 시스템에서 일반화된 가우시언라플라시안 분포 모델에 기반한 향상된 UWB 수신 방법
- 등록번호 : 10-1300037
UWB동아대학교 -
 전자.전기
전자.전기


- 박막 트랜지스터 및 그의 제조 방법
- 등록번호 : 10-1286526
박막 트랜지스터동아대학교 -
 전자.전기
전자.전기


- 현악기용 전기 브리지
- 등록번호 : 10-1335501
현악기/전기 브리지동아대학교 -
 전자.전기
전자.전기


- 공유영역 내 무선 전력 전파망을 이용한 클라우딩 충전시스템
- 등록번호 : 10-1311436
충전시스템/무선 전력 전파망동아대학교 -
 전자.전기
전자.전기


- 무접점 마그네틱 리프터
- 등록번호 : 10-1288978
리프터동아대학교 -
 전자.전기
전자.전기


- 감광막을 포함한 섀도우 마스크 및 그의 제조 방법
- 등록번호 : 10-1308497
섀도우 마스크동아대학교 -
 전자.전기
전자.전기


- 직구동형 영구자석 풍력 발전기 모델링 및 통합 시뮬레이터
- 등록번호 : 10-1219322
풍력 발전기 모델링동아대학교 -
 전자.전기
전자.전기


- 유기 박막 트랜지스터의 유기 반도체층 형성 방법, 이에 의해 형성된 유기 박막 트랜지스터, 이를 포함하는 표시 소자 및 그 표시 소자로 형성된 표시용 전자기기
- 등록번호 : 10-1288622
박막 트랜지스터동아대학교 -
 전자.전기
전자.전기


- 포락선 검파 회로 및 이를 이용한 수신 장치
- 등록번호 : 10-1274157
검파회로동아대학교 -
 전자.전기
전자.전기


- 베르누이혼합모델을 이용한 영상의 배경모델링장치 및 방법
- 등록번호 : 10-1203050
영상처리동아대학교 -
 전자.전기
전자.전기


- 개선된 전극부를 가지는 평판 표시 패널 및 이를 포함하는 평판 표시 장치
- 등록번호 : 10-1160453
평판 표시 패널동아대학교 -
 전자.전기
전자.전기


- 일반화된 정규-라플라스 분포 잡음 환경에서의 신호 검출 장치
- 등록번호 : 10-1228624
신호 검출 장치동아대학교 -
 전자.전기
전자.전기


- 횡전계 액정 모드의 광시야각 보상 방법 및 그 구조
- 등록번호 : 10-1210396
광시야각 보상동아대학교 -
 전자.전기
전자.전기


- 모세관 구동 전극형 대기압 플라즈마 제트 발생기
- 등록번호 : 10-1150387
플라즈마 제트 장치동아대학교 -
 전자.전기
전자.전기


- uDEAS를 이용한 산업용 히터 시스템의 자동 동조PID 제어 방법
- 등록번호 : 10-1721111
산업용 히터/PID 제어동아대학교 -
 항만 물류.컨테이너
항만 물류.컨테이너


- 양방향 통신을 지원하는 물류 IoT 통신 시스템 및 방법
- 등록번호 : 10-1689349
물류 IoT동아대학교 -
 항만 물류.컨테이너
항만 물류.컨테이너


- 문 개폐 감지장치 및 그것이 적용된 냉동 컨테이너
- 등록번호 : 10-1620006
컨테이너 보안동아대학교 -
 항만 물류.컨테이너
항만 물류.컨테이너


- 운영중 원격 설정 기능을 갖는 냉동컨테이너 모니터링 서버및 방법
- 등록번호 : 10-1707489
냉동컨테이너 모니터링동아대학교 -
 항만 물류.컨테이너
항만 물류.컨테이너


- 냉동컨테이너 ID 자동 등록 기능을 갖는 냉동컨테이너제어 장비 및 방법
- 등록번호 : 10-1550035
냉동컨테이너 제어동아대학교 -
 항만 물류.컨테이너
항만 물류.컨테이너


- 공간 좌표를 이용한 컨테이너의 위치를 추적하기 위한방법 및 장치
- 등록번호 : 10-1557825
컨테이너/위치추적동아대학교 -
 항만 물류.컨테이너
항만 물류.컨테이너


- 저전력 양방향 통신을 기반으로 하는 컨테이너 위치 추적 방법 및 시스템
- 등록번호 : 10-1557824
컨테이너/위치추적동아대학교 -
 항만 물류.컨테이너
항만 물류.컨테이너


- 지오펜싱 분석을 이용한 센서 제어 방법 및 장치
- 등록번호 : 10-1504555
센서제어/컨테이너 추적동아대학교 -
 항만 물류.컨테이너
항만 물류.컨테이너


- 컨테이너의 봉인 감지 시스템 및 장치
- 등록번호 : 10-1503472
컨테이너 보안/RFID동아대학교 -
 항만 물류.컨테이너
항만 물류.컨테이너


- 컨테이너 보안용 컨테이너 도어 개폐 감지장치
- 등록번호 : 10-1515913
컨테이너 보안동아대학교 -
 항만 물류.컨테이너
항만 물류.컨테이너


- 컨테이너 보안용 컨테이너 도어 개폐 감지장치
- 등록번호 : 10-1275764
컨테이너 보안동아대학교 -
 항만 물류.컨테이너
항만 물류.컨테이너


- 컨테이너 도어 개폐 감지장치
- 등록번호 : 10-1257406
컨테이너 보안동아대학교 -
 항만 물류.컨테이너
항만 물류.컨테이너


- 듀얼모드 트레일러 시스템에 있어서 화차 또는 트레일러에서 이송차량으로 또는 이송차량에서 화차 또는 트레일러로 컨테이너를 이송하는 방법
- 등록번호 : 10-1312302
컨테이너 이송동아대학교 -
 항만 물류.컨테이너
항만 물류.컨테이너


- 듀얼모드 트레일러 시스템에 있어서 슬라이딩 방식 컨테이너 이송 차량
- 등록번호 : 10-1251918
컨테이너 이송동아대학교 -
 항만 물류.컨테이너
항만 물류.컨테이너


- 시설물 구동형 컨테이너 수평 이송 시스템을 이용한컨테이너 수평 이송 방법
- 등록번호 : 10-1339155
컨테이너 이송동아대학교 -
 항만 물류.컨테이너
항만 물류.컨테이너


- 시설물 구동형 컨테이너 수평 이송 시스템
- 등록번호 : 10-1202461
컨테이너 수평 이송동아대학교 -
 항만 물류.컨테이너
항만 물류.컨테이너


- 컨테이너 보안 장치를 위한 RFID 미들웨어 시스템
- 등록번호 : 10-1139888
컨테이너 보안/RFID동아대학교 -
 자동차.교통.운송
자동차.교통.운송


- OBD 연결이 가능한 GPS 시스템 및 이를 이용한데이터 동기화 방법
- 등록번호 : 10-1689810
데이터 동기화 방법동아대학교 -
 자동차.교통.운송
자동차.교통.운송


- OBD, GPS 및 블랙박스 영상정보를 이용한 교통사고 현장재현시스템 및 그 방법
- 등록번호 : 10-1689805
교통사고 현장재현/블랙박스 영상 이용동아대학교 -
 자동차.교통.운송
자동차.교통.운송


- 베이퍼록 방지를 위한 브레이크의 냉각장치
- 등록번호 : 10-1700429
브레이크 냉각장치동아대학교 -
 자동차.교통.운송
자동차.교통.운송


- 스트럿의 휨 방지장치
- 등록번호 : 10-1620961
스트럿/휨방지동아대학교 -
 자동차.교통.운송
자동차.교통.운송


- 밸브형 서스펜션을 구비한 휠체어
- 등록번호 : 10-1676387
휠체어동아대학교 -
 자동차.교통.운송
자동차.교통.운송


- 브레이크디스크 소재의 가공성 향상을 위한 흑연화 열처리 방법
- 등록번호 : 10-1587349
브레이크디스크/ 열처리동아대학교 -
 자동차.교통.운송
자동차.교통.운송


- 노선버스 정차 및 출입문 개폐 안전 제어 시스템 및 방법
- 등록번호 : 10-1598953
출입문 개폐 안전제어동아대학교 -
 자동차.교통.운송
자동차.교통.운송


- 차량용 유니버설 너클
- 등록번호 : 10-1508365
너클동아대학교 -
 자동차.교통.운송
자동차.교통.운송


- 제동 가능한 계단용 다륜 캐리어
- 등록번호 : 10-1535257
캐리어동아대학교 -
 자동차.교통.운송
자동차.교통.운송


- 투명한 A필러 구조를 갖는 자동차
- 등록번호 : 10-1445501
A필러 구조동아대학교 -
 자동차.교통.운송
자동차.교통.운송


- 자동차용 비상 신호 장치
- 등록번호 : 10-1447698
비상 신호 장치동아대학교 -
 자동차.교통.운송
자동차.교통.운송


- 형상기억 탄성체를 내장한 자동개방형 도어록 및이를 갖는 안전도어
- 등록번호 : 10-1370538
안전도어동아대학교 -
 자동차.교통.운송
자동차.교통.운송


- 차량용 블랙박스 장치
- 등록번호 : 10-1381746
차량용 블랙박스동아대학교 -
 자동차.교통.운송
자동차.교통.운송


- 자동차 빗물 차단 장치
- 등록번호 : 10-1347246
빗물 차단 장치동아대학교 -
 자동차.교통.운송
자동차.교통.운송


- 차량의 사고위치 표시장치
- 등록번호 : 10-1308285
사고위치 표시장치동아대학교 -
 자동차.교통.운송
자동차.교통.운송


- 레이저를 이용한 차량 주행 보조 장치
- 등록번호 : 10-1303743
차량 주행 보조동아대학교 -
 자동차.교통.운송
자동차.교통.운송


- 도난 차량 추적 지원 방법과 시스템, 및 이를 지원하는 차량
- 등록번호 : 10-1288621
도난 차량 추적동아대학교 -
 자동차.교통.운송
자동차.교통.운송


- 자동차의 전원 제어 시스템 및 방법
- 등록번호 : 10-1160549
차량 전원 제어동아대학교 -
 자동차.교통.운송
자동차.교통.운송


- 고강도 및 경량의 헤드 레스트 스테이의 제조방법
- 등록번호 : 10-1142979
헤드 레스트 스테이동아대학교 -
 기계.금속
기계.금속


- 유리컵 성형기
- 등록번호 : 10-1731487
유리컵 성형기동아대학교 -
 기계.금속
기계.금속


- 타격식 해머 공구
- 등록번호 : 10-1711113
해머공구동아대학교 -
 기계.금속
기계.금속


- 교체가 용이한 모듈식 탑 엔트리 타입 볼 밸브
- 등록번호 : 10-1733997
볼 밸브동아대학교 -
 기계.금속
기계.금속


- 셔터 슬라이드형 밸브
- 등록번호 : 10-1730082
밸브동아대학교 -
 기계.금속
기계.금속


- 잭업 리그의 통합 모니터링 장치 및 방법
- 등록번호 : 10-1707151
모니터링/잭업리그동아대학교 -
 기계.금속
기계.금속


- 캐비테이션 방지 기능을 갖는 밸브 디스크 및이를 구비한 버터플라이밸브
- 등록번호 : 10-1674531
버터플라이 밸브동아대학교 -
 기계.금속
기계.금속


- 다공성 디스크를 포함하는 글로브밸브
- 등록번호 : 10-1711558
글로브 밸브동아대학교 -
 기계.금속
기계.금속


- 전기구동 터렛 시스템 및 그 작동방법
- 등록번호 : 10-1682558
터렛동아대학교 -
 기계.금속
기계.금속


- 아이형 디스크로 이중차단 구조를 갖는 글로브밸브
- 등록번호 : 10-1713229
글로브 밸브동아대학교 -
 기계.금속
기계.금속


- 3웨이 양날 제어 밸브
- 등록번호 : 10-1666555
밸브동아대학교 -
 기계.금속
기계.금속


- 저토크 및 절수를 위한 단일방향 회전하는 수도꼭지 밸브
- 등록번호 : 10-1716354
밸브동아대학교 -
 기계.금속
기계.금속


- 공작 기계의 전기 구동 장치 및 방법
- 등록번호 : 10-1639688
축 구동장치동아대학교 -
 기계.금속
기계.금속


- 스토퍼 체크 밸브
- 등록번호 : 10-1731955
체크밸브동아대학교 -
 기계.금속
기계.금속


- 온도센서와 펌프를 이용한 온수조절 밸브 시스템
- 등록번호 : 10-1654166
밸브동아대학교 -
 기계.금속
기계.금속


- 동파 방지 밸브 시스템
- 등록번호 : 10-1638785
동파 방지 밸브동아대학교 -
 기계.금속
기계.금속


- 체크밸브
- 등록번호 : 10-1601853
체크밸브동아대학교 -
 기계.금속
기계.금속


- 이중 볼 밸브
- 등록번호 : 10-1601850
볼 밸브동아대학교 -
 기계.금속
기계.금속


- 유량 제어를 위한 이중 볼 밸브
- 등록번호 : 10-1601846
볼 밸브동아대학교 -
 기계.금속
기계.금속


- 디스크의 구동을 전자기력으로 보조하는 글로브밸브
- 등록번호 : 10-1660800
글로브 밸브동아대학교 -
 기계.금속
기계.금속


- 디스크에 튜브가 결합된 글로브밸브
- 등록번호 : 10-1601845
글로브 밸브동아대학교 -
 기계.금속
기계.금속


- 서브게이트를 구비한 버터플라이 밸브
- 등록번호 : 10-1584344
버터플라이 밸브동아대학교 -
 기계.금속
기계.금속


- 버터플라이밸브 및 그 작동방법
- 등록번호 : 10-1591375
버터플라이 밸브동아대학교 -
 기계.금속
기계.금속


- 원격제어형 피칭머신
- 등록번호 : 10-1579903
피칭머신동아대학교 -
 기계.금속
기계.금속


- 가공기계용 축 구동장치
- 등록번호 : 10-1504286
축 구동장치동아대학교 -
 기계.금속
기계.금속


- 저 망간 트윕강의 제조방법
- 등록번호 : 10-1612180
저망간 강제조동아대학교 -
 기계.금속
기계.금속


- ORC 발전 시스템용 터빈
- 등록번호 : 10-1669519
터빈동아대학교 -
 기계.금속
기계.금속


- 볼조인트의 유격 및 토크 측정 장치 및 방법
- 등록번호 : 10-1551855
토크측정장치/볼조인트동아대학교 -
 기계.금속
기계.금속


- 동축 마그네틱 기어
- 등록번호 : 10-1537046
마그네틱 기어동아대학교 -
 기계.금속
기계.금속


- 버터플라이밸브
- 등록번호 : 10-1512452
버터플라이 밸브동아대학교 -
 기계.금속
기계.금속


- 버터플라이 밸브
- 등록번호 : 10-1507970
버터플라이 밸브동아대학교 -
 기계.금속
기계.금속


- 더블 디스크를 구비한 미닫이형 게이트 밸브
- 등록번호 : 10-1542193
게이트 밸브동아대학교 -
 기계.금속
기계.금속


- 유량조절용 가변스토퍼를 구비한 스윙식 체크밸브
- 등록번호 : 10-1476364
체크밸브동아대학교 -
 기계.금속
기계.금속


- 링크구조형 유량조절밸브
- 등록번호 : 10-1512447
유량조절밸브동아대학교 -
 기계.금속
기계.금속


- 실용형 유압식 고정 피스톤 샘플러
- 등록번호 : 10-1547578
고정 피스톤 샘플러동아대학교 -
 기계.금속
기계.금속


- 벨로우즈 타입 안전밸브
- 등록번호 : 10-1507461
안전밸브동아대학교 -
 기계.금속
기계.금속


- 파일럿 밸브의 밸브 스템 어셈블리
- 등록번호 : 10-1507459
파일럿 밸브동아대학교 -
 기계.금속
기계.금속


- 에스피엠용 프로세싱 장치
- 등록번호 : 10-1511360
프로세싱 장치동아대학교 -
 기계.금속
기계.금속


- 크랭크 샤프트의 고유진동수를 측정하기 위한모달 테스팅용 지그
- 등록번호 : 10-1526511
지그/크랭크 샤프트동아대학교 -
 기계.금속
기계.금속


- 이동식 메탈 실 게이트 밸브
- 등록번호 : 10-1478163
게이트 밸브동아대학교 -
 기계.금속
기계.금속


- 압력강하를 감소시키기 위한 필터를 갖는 스트레이너
- 등록번호 : 10-1458423
스트레이너동아대학교 -
 기계.금속
기계.금속


- 밸브 디스크 및 이를 사용한 버터플라이 밸브
- 등록번호 : 10-1402900
버터플라이 밸브동아대학교 -
 기계.금속
기계.금속


- 듀플렉스 스테인리스강 용접봉 조성물
- 등록번호 : 10-1550856
용접봉 조성물동아대학교 -
 기계.금속
기계.금속


- 가공기계용 축 구동장치
- 등록번호 : 10-1476361
축 구동장치동아대학교 -
 기계.금속
기계.금속


- 박스 이송용 장치
- 등록번호 : 10-1420819
박스 이송용 장치동아대학교 -
 기계.금속
기계.금속


- 점성 유체의 감쇠 계수 측정 장치
- 등록번호 : 10-1433282
감쇠 계수 측정 장치동아대학교 -
 기계.금속
기계.금속


- 코일을 이용한 버터플라이 밸브
- 등록번호 : 10-1431552
버터플라이밸브동아대학교 -
 기계.금속
기계.금속


- 조립식 버터플라이 밸브
- 등록번호 : 10-1260868
버터플라이밸브동아대학교 -
 기계.금속
기계.금속


- 바이메탈을 이용한 유로제어 밸브
- 등록번호 : 10-1392938
유로제어밸브동아대학교 -
 기계.금속
기계.금속


- 버터플라이밸브의 실링장치
- 등록번호 : 10-1303745
버터플라이 밸브동아대학교 -
 기계.금속
기계.금속


- 밸브핸들 작동용 반력지지장치
- 등록번호 : 10-1405861
밸브동아대학교 -
 기계.금속
기계.금속


- 전자석을 이용한 용접물 얼라인먼트장치
- 등록번호 : 10-1401074
용접/얼라인먼트동아대학교 -
 기계.금속
기계.금속


- 전자석을 이용한 용접물 맞대기장치
- 등록번호 : 10-1398443
용접/얼라인먼트동아대학교 -
 기계.금속
기계.금속


- 버터플라이밸브용 경량디스크 및 상기 경량디스크를 구비한버터플라이밸브
- 등록번호 : 10-1390640
버터플라이 밸브동아대학교 -
 기계.금속
기계.금속


- 버터플라이밸브용 디스크 및 이를 갖는 버터플라이밸브
- 등록번호 : 10-1333817
버터플라이 밸브동아대학교 -
 기계.금속
기계.금속


- 선형기어 모듈 및 이를 이용한 선형 액추에이터
- 등록번호 : 10-1331929
선형 액추에이터동아대학교 -
 기계.금속
기계.금속


- 정수기용 온수밸브
- 등록번호 : 10-1367169
온수밸브동아대학교 -
 기계.금속
기계.금속


- 정수기용 온수밸브
- 등록번호 : 10-1362000
온수밸브동아대학교 -
 기계.금속
기계.금속


- 리니어 액추에이터
- 등록번호 : 10-1356765
선형 액추에이터동아대학교 -
 기계.금속
기계.금속


- 리니어 액추에이터
- 등록번호 : 10-1331931
선형 액추에이터동아대학교 -
 기계.금속
기계.금속


- 고면압강도, 고강도 및 고내식성 철강부품의 제조방법
- 등록번호 : 10-1269573
철강부품동아대학교 -
 기계.금속
기계.금속


- 캐비테이션 방지 기능을 갖는 버터플라이 밸브
- 등록번호 : 10-1364676
버터플라이 밸브동아대학교 -
 기계.금속
기계.금속


- 냉각 안전밸브 장치
- 등록번호 : 10-1161793
안전밸브동아대학교 -
 기계.금속
기계.금속


- 전자석 스토퍼를 구비한 버터플라이 밸브
- 등록번호 : 10-1202464
버터플라이 밸브동아대학교 -
 기계.금속
기계.금속


- 유량차단 밸브
- 등록번호 : 10-1180991
유량차단밸브동아대학교 -
 기계.금속
기계.금속


- 플로팅밸브
- 등록번호 : 10-1172525
플로팅밸브동아대학교 -
 기계.금속
기계.금속


- 응급정비 및 누유 데이터 확인이 가능한 다용도 보강재
- 등록번호 : 10-1192427
보강재동아대학교 -
 기계.금속
기계.금속


- 다방향 제어가 가능한 멀티 밸브
- 등록번호 : 10-1380824
밸브동아대학교 -
 기계.금속
기계.금속


- 판형 열교환기
- 등록번호 : 10-1307786
열교환기동아대학교 -
 기계.금속
기계.금속


- 교반장치의 동력전달용 기어 어셈블리 및이를 구비한 교반장치
- 등록번호 : 10-1318876
교반장치/기어어셈블리동아대학교 -
 기계.금속
기계.금속


- 교반장치용 웨이트 밸런스 및 이를 구비한 교반장치 및교반장치의 상부 어셈블리 승강방법
- 등록번호 : 10-1318872
교반장치/기어어셈블리동아대학교 -
 기계.금속
기계.금속


- 영구자석형 전동기
- 등록번호 : 10-1243303
모터동아대학교 -
 기계.금속
기계.금속


- 차량용 고수명 볼 조인트
- 등록번호 : 10-1260866
볼조인트동아대학교 -
 기계.금속
기계.금속


- 형상기억합금 와이어를 이용한 자동온도감지 개폐밸브및 밸브 개폐방법
- 등록번호 : 10-1199579
밸브동아대학교 -
 기계.금속
기계.금속


- 조리개형 밸브
- 등록번호 : 10-1173307
밸브동아대학교 -
 기계.금속
기계.금속


- 마이크로채널 에어 밸브
- 등록번호 : 10-1176949
밸브동아대학교 -
 기계.금속
기계.금속


- 가변익 터빈 밸브
- 등록번호 : 10-1176008
밸브동아대학교 -
 기계.금속
기계.금속


- 이중 개폐형 디스크를 갖는 버터플라이밸브
- 등록번호 : 10-1173306
버터플라이밸브동아대학교 -
 기계.금속
기계.금속


- 탈취필터 관능시험장치
- 등록번호 : 10-1218109
탈취필터/관능시험동아대학교 -
 기계.금속
기계.금속


- 도로용 소형발전장치
- 등록번호 : 10-1218059
소형발전장치동아대학교 -
 기계.금속
기계.금속


- 수공발파용 자립에어튜브
- 등록번호 : 10-1263902
에어튜브/수공발파동아대학교 -
 기계.금속
기계.금속


- 형상기억합금용 복사식 비례제어 열처리장치
- 등록번호 : 10-1217845
열처리 장치동아대학교 -
 기계.금속
기계.금속


- 교류삼투유동과 경사전극 패턴을 이용한 마이크로 채널형유체 혼합기
- 등록번호 : 10-1203048
유체혼합기동아대학교 -
 기계.금속
기계.금속


- 유량조절용 이중 볼밸브
- 등록번호 : 10-1165366
볼밸브동아대학교 -
 기계.금속
기계.금속


- 중력을 이용한 압연유 분사장치
- 등록번호 : 10-1165367
분사장치동아대학교 -
 기계.금속
기계.금속


- 원형 냉장고
- 등록번호 : 10-1173308
냉장고동아대학교 -
 기계.금속
기계.금속


- 내식성과 내오염성이 우수한 경량 가드레일 및 그의 제조 방법
- 등록번호 : 10-1149405
가드레일동아대학교 -
 기계.금속
기계.금속


- 스핀들이 6개인 멀티 스핀들 가공기
- 등록번호 : 10-1152785
스핀들 가공기동아대학교 -
 기계.금속
기계.금속


- 스핀들이 4개인 멀티 스핀들 가공기
- 등록번호 : 10-1152784
스핀들 가공기동아대학교 -
 기계.금속
기계.금속


- 스핀들이 2개인 멀티 스핀들 가공기
- 등록번호 : 10-1152779
스핀들 가공기동아대학교
